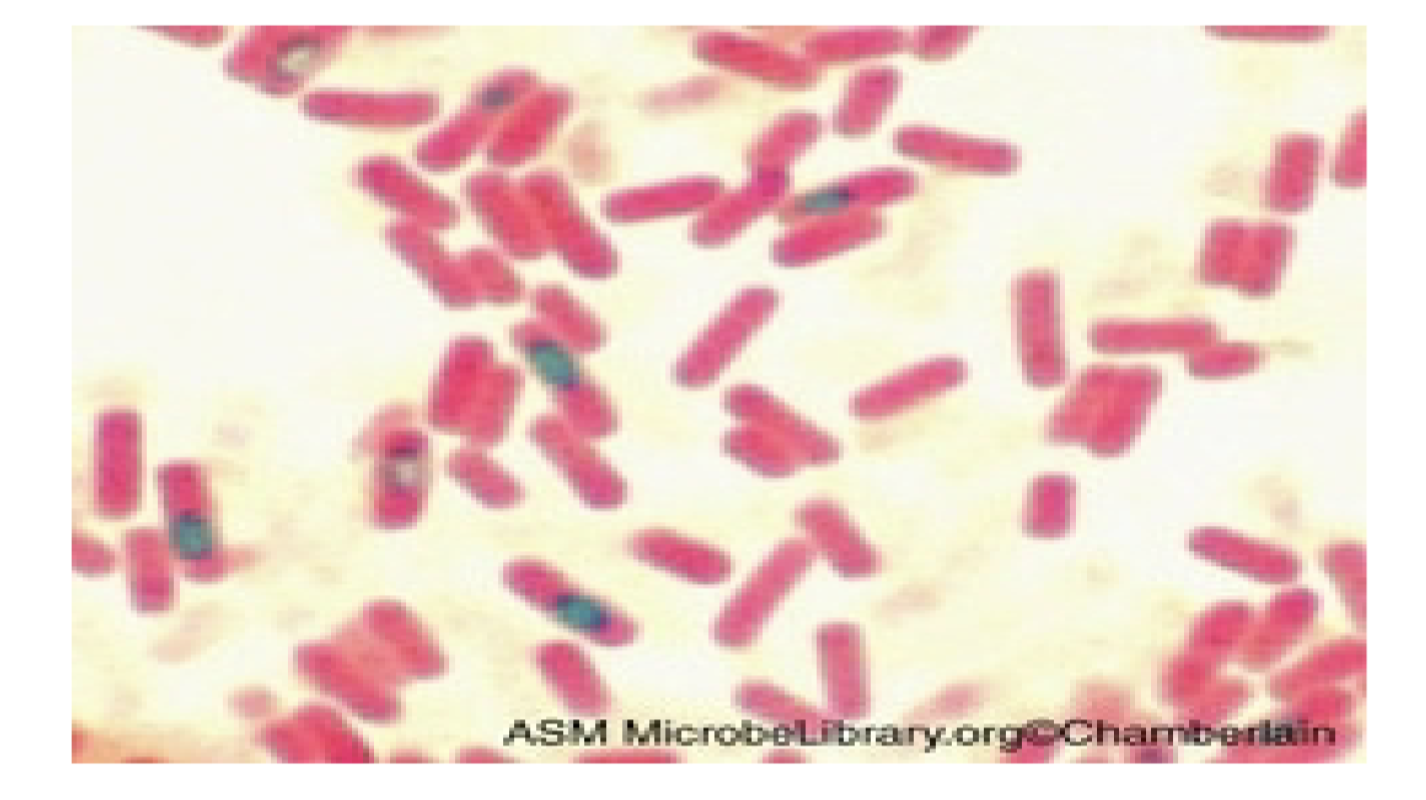
<p>what are the pink and green</p>
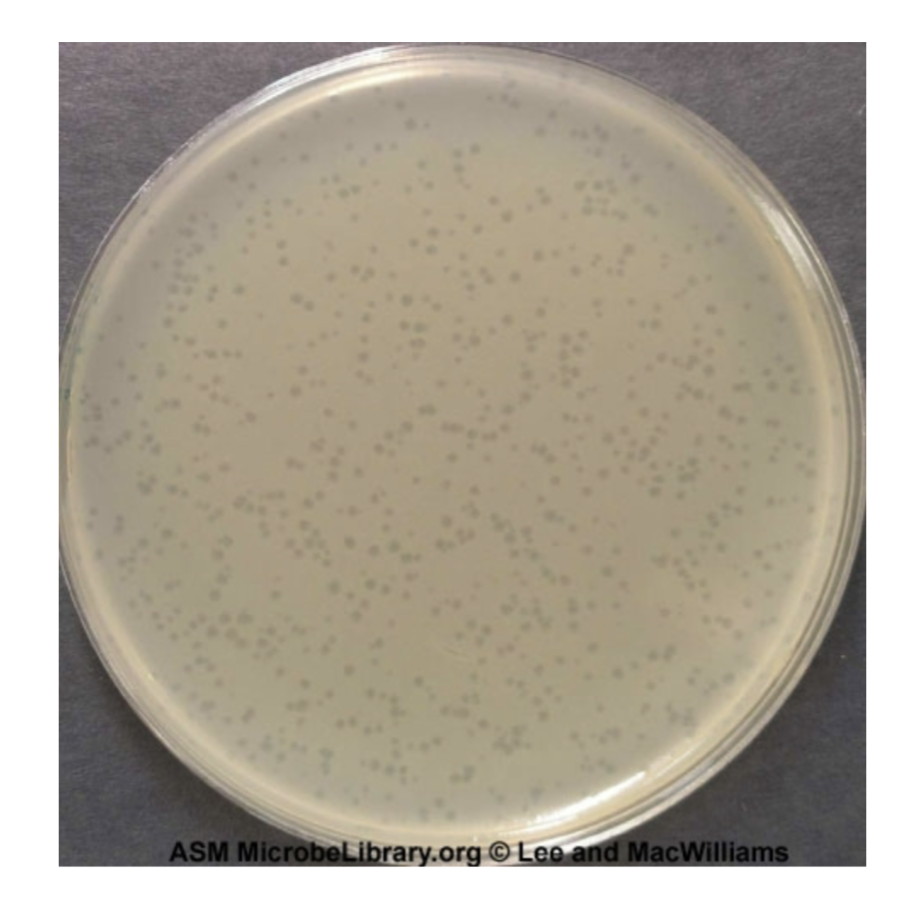
<p>what are the clear spots and what are they caused by</p>
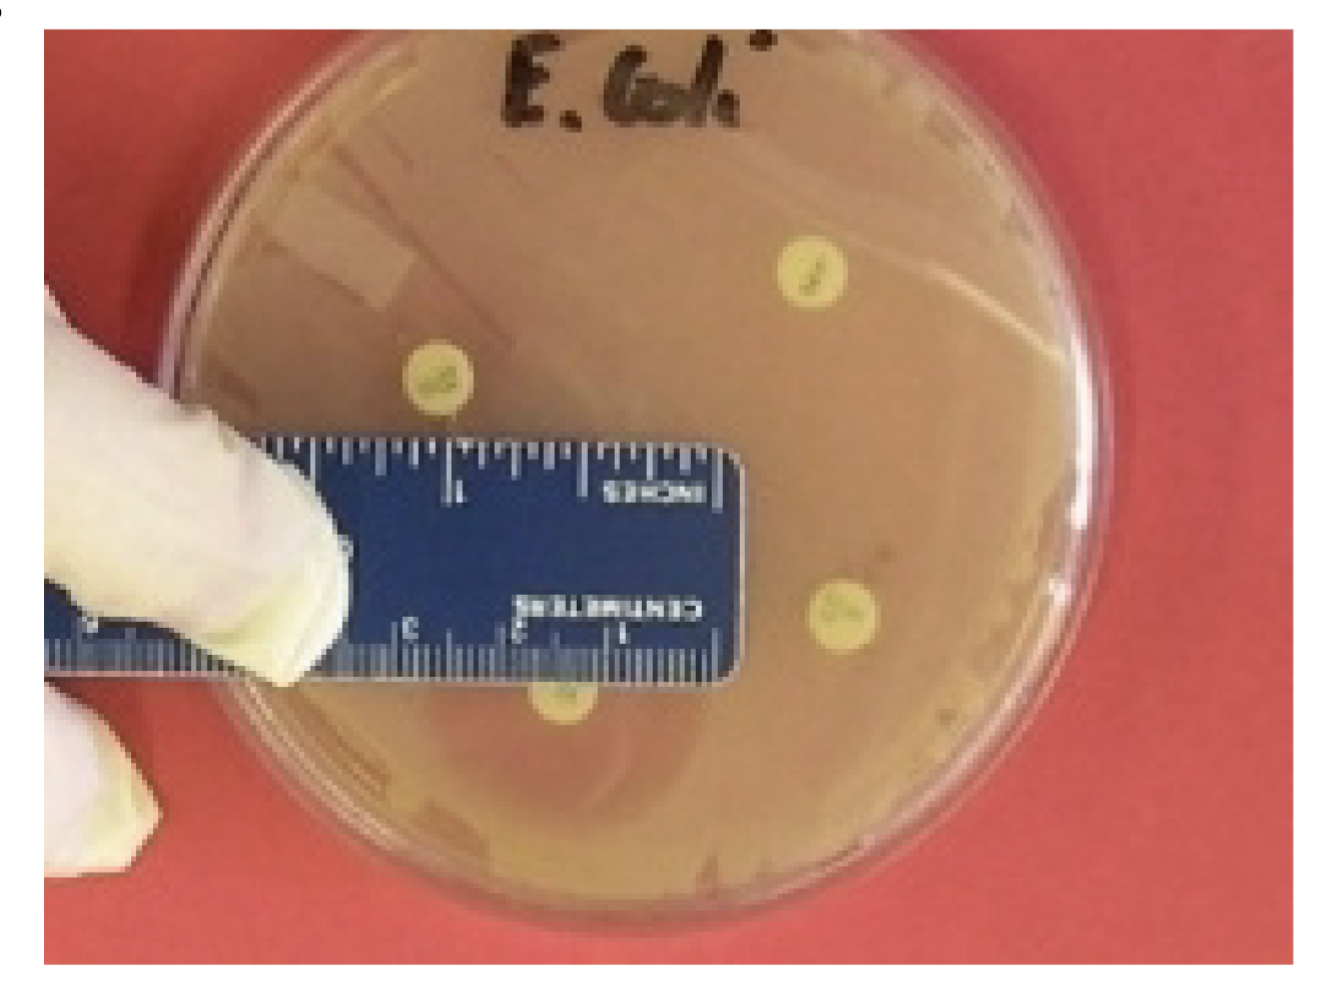
<p>what is the size (hard to tell)</p>
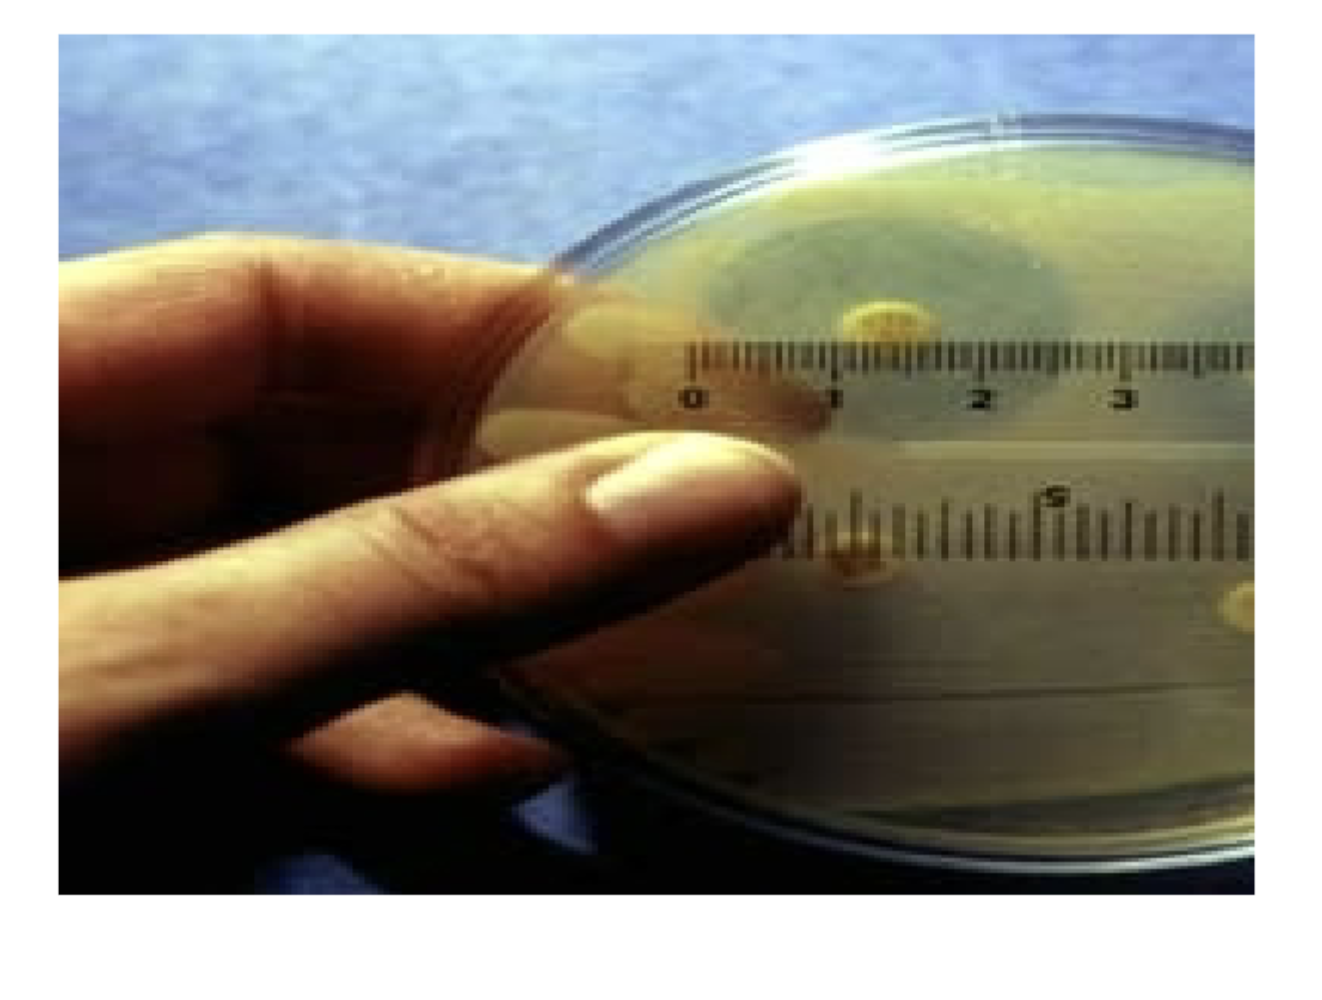
<p>what is the size (hard to tell)</p>
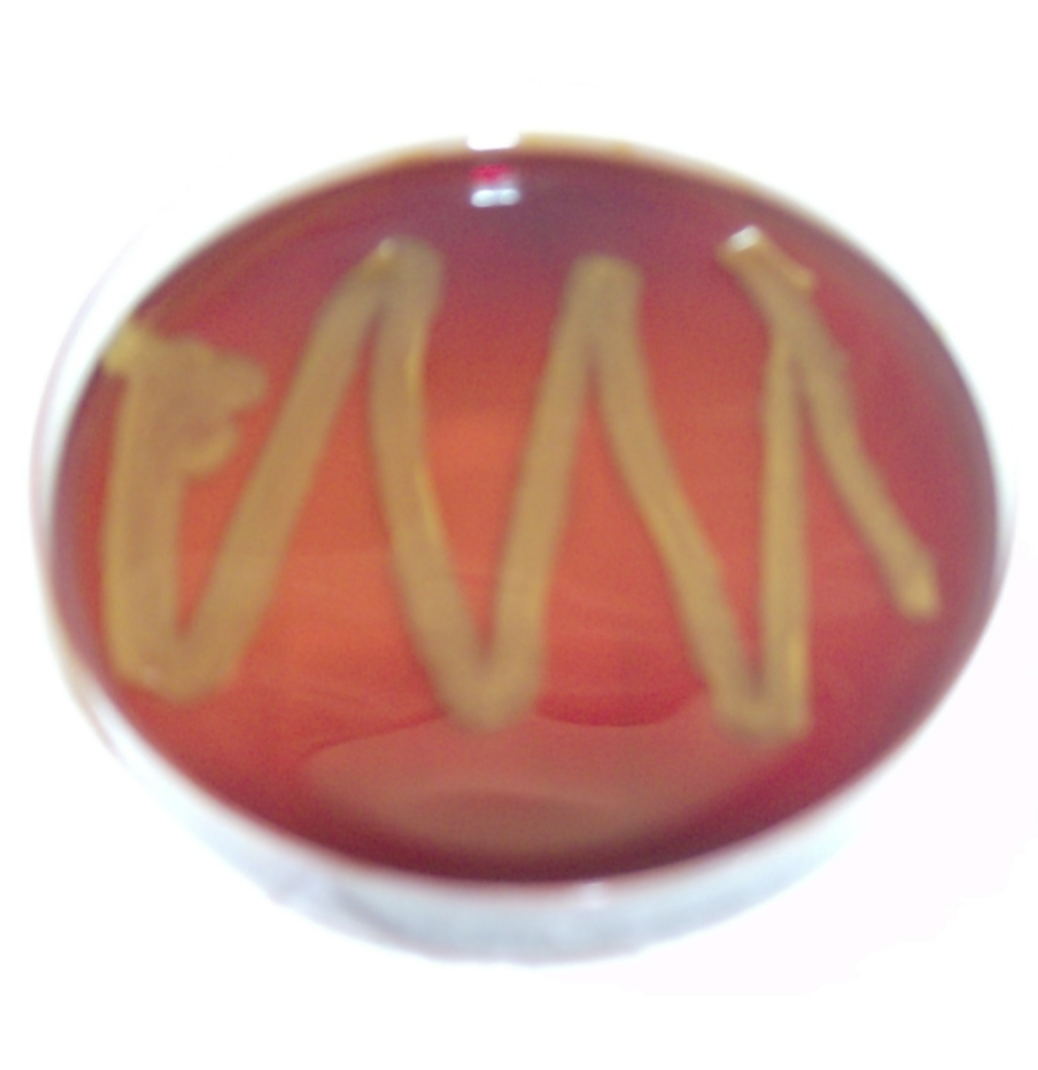
<p>what is the test and result?</p>

1/31
Looks like no tags are added yet.
Name | Mastery | Learn | Test | Matching | Spaced | Call with Kai |
|---|
No analytics yet
Send a link to your students to track their progress
Gram-positive cocci
positive/negative and morphology

Gram-negative bacilli
positive/negative and morphology

Gram-positive bacilli
positive/negative and morphology

acid-fast positive, bacilli
positive/negative and morphology

acid-fast negative, bacilli
positive/negative and morphology

bacilli with capsule
what is this and morphology

vegetative bacilli and endospores
what are the pink and green
phenol
which chemical is more effective

plaques, bacteriophages
what are the clear spots and what are they caused by
around 27 mm
what is the size (hard to tell)
about 9 mm
what is the size (hard to tell)

about 27 mm
what is the size (hard to tell)
pili or fimbriae
what are the hairs on the plushie called

sugar fermentation, acid negative and gas negative
what is the test and result?

sugar fermentation, acid positive and gas negative
what is the test and result?

sugar fermentation, acid positive and gas positive
what is the test and result?

catalase, positive
what is the test and result?

catalase, negative
what is the test and result?

citrate, negative
what is the test and result?

citrate, positive
what is the test and result?

H2S test, negative
what is the test and result?

H2S test, positive
what is the test and result?

indole test, positive
what is the test and result?

indole test, negative
what is the test and result?

starch test, negative
what is the test and result?

starch test, positive
what is the test and result?
THIO test, obligate aerobe
what is the test and result?

THIO test, facultative anaerobe
what is the test and result?

TTC test, nonmotile
what is the test and result?

TTC test, motile
what is the test and result?

urea test, positive
what is the test and result?

urea test, negative
what is the test and result?
